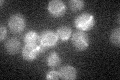
YOR040W
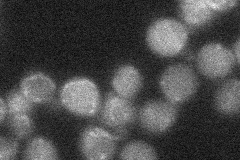
YOR040W
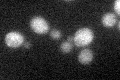
YOR040W

View description
Mitochondrial glyoxalase II, catalyzes the hydrolysis of S-D-lactoylglutathione into glutathione and D-lactate
Localization:
Intensity:
Fold change:
Significance:
-
C’ GFP library in SD
mitochondria18.6 -
N' NOP1pr-GFP in SD

mitochondria105.297 -
N' TEF2pr-mCherry in SD

punctate,mitochondria6.79132 -
N' NATIVEpr-GFP in SD
mitochondria19.2395 -
N' TEF2pr-VC and Cyto-VN in SD

#N/A0 -
C’ GFP library in SD+DTT
mitochondria20.161.08No -
C’ GFP library in SD+H2O2

mitochondria19.951.07No -
C’ GFP library in Starvation Media

mitochondria21.061.13No -
C’ GFP library on the background of Pup2-DaMP

mitochondria -
C’ GFP library on the background of CCT mutant

mitochondria19.46571.04635No
